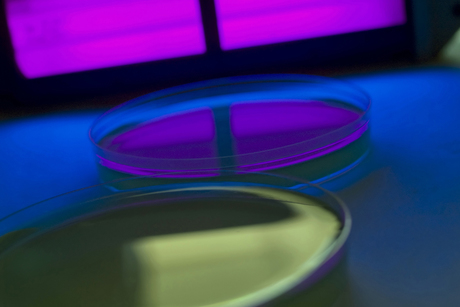

NCRIS funding secured
Funding of the National Collaborative Research Infrastructure Strategy (NCRIS) will continue in the short term, with the Australian Government securing a further 12 months of funding for the scheme.
Australia’s major national research facilities can now breathe easier with the government backing away from linking NCRIS funding to the passage of higher education reforms through the Senate - the proposed deregulation of the university sector was voted down this week.
The funding decision follows numerous approaches to the government from across the science community and business sector warning that uncertainty over NCRIS funding from 1 July put over $2 billion of public investment at risk and several facilities were likely to shut down.
The Australian Academy of Science’s President Professor Andrew Holmes welcomed the announcement.
“This decision will mean researchers can get on with the job of developing the new technology and innovative ideas that Australia needs for the future,” said Holmes in a statement.
“It means they are back from the brink of closure. Now what we need to see is long-term funding for this essential infrastructure that gives researchers and industry in Australia the certainty they need.”
Introduced by the Howard Government in 2004, $150 million a year is distributed through NCRIS to fund facilities that provide services to other researchers. Since 2004, about $2.5 billion has been invested in national research infrastructure.
The 2015-16 funding will allow the continued operation of 27 facilities that support fundamental and applied research across Australia; for example, in molecular bioscience and big data, medical research and biosecurity.
NCRIS-funded facilities directly employ 1700 highly skilled staff that support the work of more than 35,000 researchers in Australia and overseas.
The scheme provides researchers with access to world-class infrastructure, a much-needed service given the small size of Australia’s research community. NCRIS has also been a resounding success in contributing to world-class research around the country.
In the longer term, a review of infrastructure requirements for Australia is underway with the Research Infrastructure Review. The review will aim to understand the investment needed to support national science infrastructure and where to make this investment
Could this psychedelic compound reduce post-concussion symptoms?
Few effective therapies exist for concussion. Now, an Australian clinical trial is exploring...
Turning point — optimal antibiotics for golden staph bloodstream infections
Involving more than 150 hospitals across more than 14 countries, a global clinical trial supports...
Alloy implants that naturally dissolve after healing
Australian researchers have been developing biodegradable magnesium-based alloys that more...



